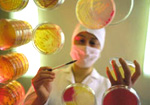
Γεγονός η πρώτη τράπεζα αρχέγονων κυττάρων στη Βρετανία

Γεγονός η πρώτη καρδιολογική επέμβαση από τηλεχειριζόμενο ρομπότ
Λονδίνο: Ιατρική ομάδα του βρετανικού Νοσοκομείου του Λέστερ πραγματοποίησαν την πρώτη χειρουργική επέμβαση σε καρδιά ασθενούς, χρησιμοποιώντας εξ αποστάσεως ένα τηλεχειριζόμενο ρομπότ.

Αριθμός Πιστοποίησης Μ.Η.Τ.232442
Αριθμός Πιστοποίησης Μ.Η.Τ.232442